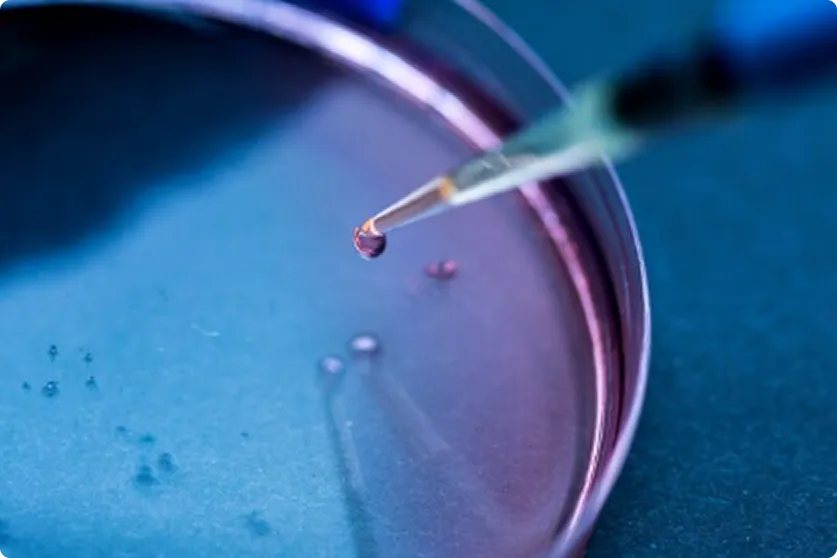

ELISA Kit
Explore Our Range of ELlSA Kits for veterinary Disease Detection, Vaccine Ethcacy Monitonng,and bisecunty Solutions.

No complex equipment needed - 5-minute accurate reading with <0.5% error rate! Brings lab-grade testing to veterinary clinics, livestock farming, and disease prevention scenarios. Internationally certified, upholding gold-standard health protection to make professional diagnostics accessible to all.
| Product Number | TE-TE-0002 |
| Product Name | Equine Infectious Anemia Virus Antibody Colloidal Gold Immunochromatography Test Kit |
| principle | CGICA |
| Animal | Equine |
| Specifications | 50T/BOX |
| Test sample | Serum |
| Storage and shelf life | 2-30°C, 12 months |
| Intended use | This product is intended for the detection of Equine Infectious Anemia Virus (EIAV) antibodies in equine serum. |
| Certificate | IS0 9001& GMP-compliant Manufacturing Enterprises & CNAS L12385 |
| Equine Infectious Anemia Virus Antibody Colloidal Gold Immunochromatography Test Kit | 50 strip/box*1 |
| 02-Instructions | 1 serving |
Delivers clear, visible results within 5–15 minutes.
Enables testing in remote locations, at farms, or at the point of entry.
Requires only a small sample (e.g., blood, serum, or swab
Accurately detects target antigens or antibodies for reliable decision-making.
This product comes with a dedicated sample diluent. Do not use diluent from other sources.
After adding the sample and diluent to Sample Well 1 and Sample Well 2 respectively, if antibodies against Equine Infectious Anemia Virus (EIAV) are present in the sample, they will bind to the colloidal gold-labeled anti-horse IgG antibody, forming a complex that migrates along the chromatographic membrane. The complex is then captured by the EIAV-specific antigen pre-coated on the membrane, resulting in a wine-red detection line at the T position of the test card. If no EIAV antibodies are present in the sample, no visible line will appear at the T position.

Enables immediate detection of disease threats at farms, markets, and checkpoints.

Ensures compliance with animal health regulations during animal movement.

Supports herd health management and outbreak response.

Provides a convenient tool for rapid sample evaluation and pre-laboratory screening.
We will reply you within 24 hours. If for urgent case, please add WhatsApp: +8610522552255 or WeChat:+86 15776899176. Or cal+8610522552255 directly.
*We respect your confidentiality and all information are protected. We will only use your information to respond to your inquiry and will never send unsolicited emails or promotional messages.
We will reply you within 24 hours. If for urgent case, please add WhatsApp/WeChat: +86 19577776076,. Or call +86 15776899176 directly.
*We respect your confidentiality and all information are protected.
We will only use your information to respond to your inquiry and will never send unsolicited emails or promotional messages.